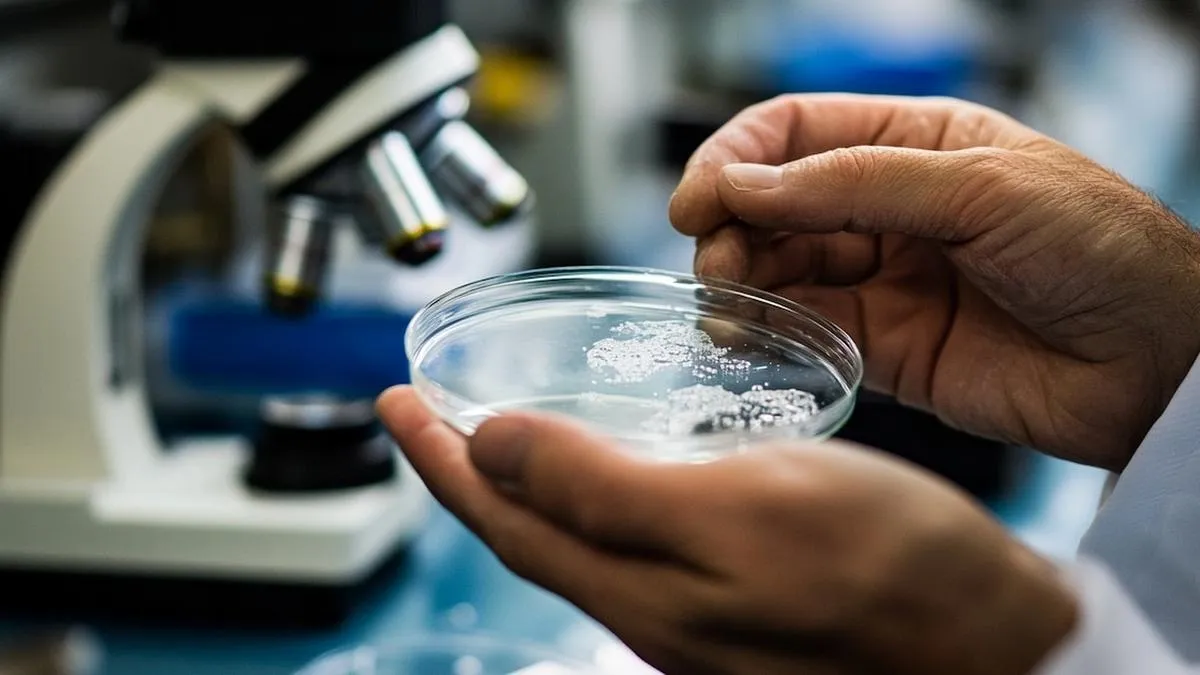
Nanotecnología avanza en tratamientos innovadores para obesidad y enfermedades intestinales según estudios recientes de la UNAM

La ciencia avanza rápidamente hacia nuevas fronteras gracias, entre otras cosas, a la nanotecnología. Según la Universidad Nacional Autónoma de México (UNAM), el objetivo de esta disciplina es entender, caracterizar, manipular y explotar “las características físicas de la materia a nanoescala para proponer verdaderas soluciones de impacto social y tecnológico”. En este contexto, dos estudios recientes han sido realizados por científicos que exploran enfoques innovadores para abordar problemas de salud utilizando nanopartículas y bacterias modificadas. A continuación, se presenta un repaso por ambos hallazgos.
Etiqueta: nanopartículas
Mascarillas chilenas con nanopartículas de cobre eliminan el COVID-19
Un estudio de la Universidad de Berna, en Suiza, logró determinar que las mascarillas chilenas fabricadas por The Copper Company eliminan casi todo rastro del coronavirus en un máximo de 2 horas.
Continua leyendo Mascarillas chilenas con nanopartículas de cobre eliminan el COVID-19